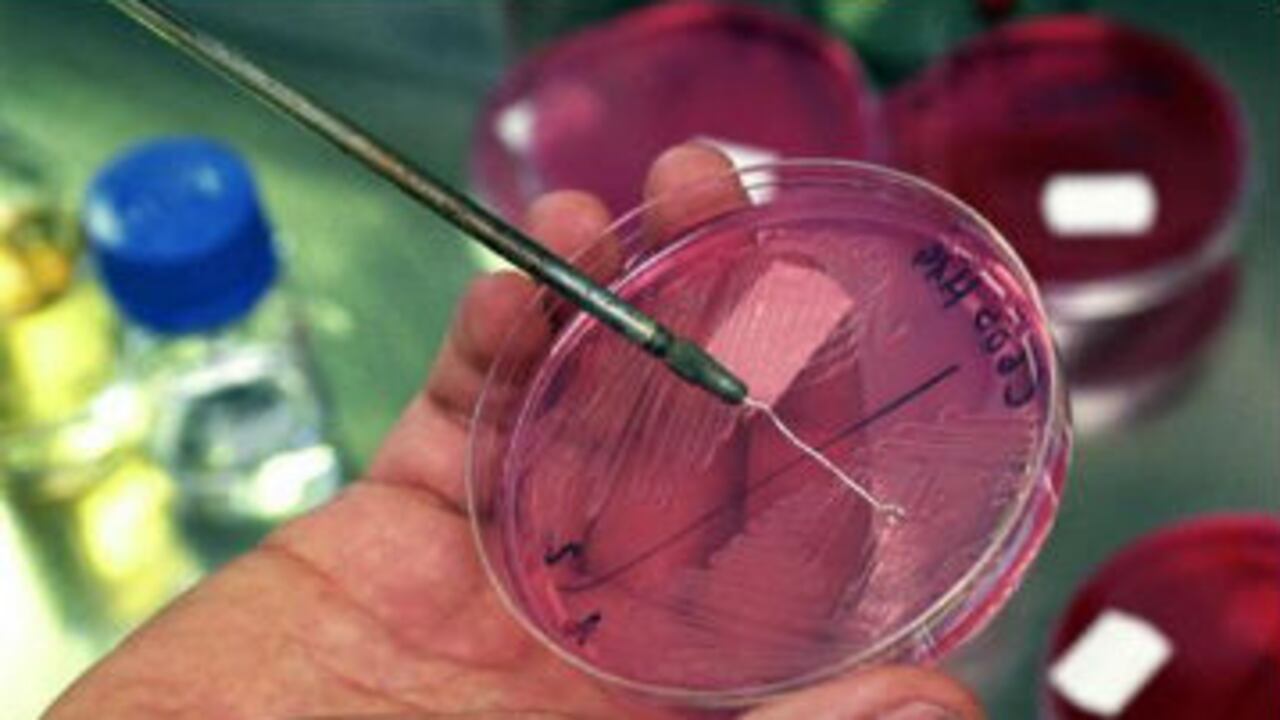
La tuberculosis está considerada como una enfermedad silenciosa pero mortal.

A nivel mundial, la tuberculosis está entre las enfermedades más extendidas: cerca de 2.000 millones de personas en todo el mundo han contraído el patógeno, aunque la enfermedad sólo se manifiesta en un porcentaje relativamente pequeño.
Un cuerpo sano puede mantener la condición a raya en la mayoría de los casos, pero la gente con sistemas inmunológicos débiles suelen ser víctimas de esta enfermedad.
Ya se cumplieron 130 años desde que el científico alemán Robert Koch describió por primera vez en 1882 el patógeno “Mycrobacterium tuberculosis”. Exactamente cien años después, en 1982, la Organización Mundial de la Salud declaró el 24 de marzo el día mundial de la tuberculosis para concienciar a la gente de los peligros de esta enfermedad.
Perfil de víctima
Con cerca de 9 millones de pacientes en todo el mundo y algunos millones muriendo por su causa cada año, la enfermedad bacterial de tuberculosis puede llamarse “la enfermedad de los pobres”. Los habitantes de los países en vías de desarrollo son los que más la sufren: la falta de alimento o las malas condiciones higiénicas hacen que las bacterias lo tengan fácil a la hora de atacar.
Y lo mismo ocurre con personas con sistemas inmunológicos débiles, como en el caso de las personas con SIDA.
Según el Informe de Tuberculosis del Instituto Robert Koch que se publicó el pasado 19 de marzo, el número de nuevos contagios en todo el mundo se ha reducido. Pero eso no significa que podamos generalizar, según el doctor Walter Haas, científico del campo de la epidemiología de enfermedades respiratorias.
En sus palabras, la prevención es clave: “La tuberculosis puede manifestarse años, incluso siglos después de un contagio. Y eso significa que los casos de infección que estamos impidiendo hoy también los estamos impidiendo para el día de mañana.”
Un resfriado muy traicionero
La tuberculosis se transmite de forma similar que un resfriado o una gripe, y puede llegar a contaminar más del 80% de los pulmones. El desarrollo de la enfermedad puede ser muy diverso: cansancio, falta de apetito, inflamación de los ganglios linfáticos, fiebre, tos, todo ello puede estar entre los síntomas de la tuberculosis. En los casos más graves se pueden dar expectoraciones de sangre, pérdidas dramáticas de peso o incluso puede llevar a una meningitis, coma y, en último caso, a la muerte.
Todo depende de lo tempranamente que se detecte la enfermedad y de su tratamiento con antibióticos. Un tratamiento definitivamente anticuado, según el doctor Sebastian Dietrich, de la organización “Médicos sin fronteras”: “Los medicamentos que hoy utilizamos para tratar la tuberculosis (y en esto no importa si estamos hablando de Alemania o de países del Tercer Mundo) fueron desarrollados entre 1944 y 1966.
Esto significa que tienen medio siglo de antigüedad, y desde entonces no se ha dado realmente ningún otro medicamento que funcione”.
Un cuerpo sano puede mantener la condición a raya en la mayoría de los casos, pero la gente con sistemas inmunológicos débiles suelen ser víctimas de esta enfermedad.
Ya se cumplieron 130 años desde que el científico alemán Robert Koch describió por primera vez en 1882 el patógeno “Mycrobacterium tuberculosis”. Exactamente cien años después, en 1982, la Organización Mundial de la Salud declaró el 24 de marzo el día mundial de la tuberculosis para concienciar a la gente de los peligros de esta enfermedad.
Perfil de víctima
Con cerca de 9 millones de pacientes en todo el mundo y algunos millones muriendo por su causa cada año, la enfermedad bacterial de tuberculosis puede llamarse “la enfermedad de los pobres”. Los habitantes de los países en vías de desarrollo son los que más la sufren: la falta de alimento o las malas condiciones higiénicas hacen que las bacterias lo tengan fácil a la hora de atacar.
Y lo mismo ocurre con personas con sistemas inmunológicos débiles, como en el caso de las personas con SIDA.
Según el Informe de Tuberculosis del Instituto Robert Koch que se publicó el pasado 19 de marzo, el número de nuevos contagios en todo el mundo se ha reducido. Pero eso no significa que podamos generalizar, según el doctor Walter Haas, científico del campo de la epidemiología de enfermedades respiratorias.
En sus palabras, la prevención es clave: “La tuberculosis puede manifestarse años, incluso siglos después de un contagio. Y eso significa que los casos de infección que estamos impidiendo hoy también los estamos impidiendo para el día de mañana.”
Un resfriado muy traicionero
La tuberculosis se transmite de forma similar que un resfriado o una gripe, y puede llegar a contaminar más del 80% de los pulmones. El desarrollo de la enfermedad puede ser muy diverso: cansancio, falta de apetito, inflamación de los ganglios linfáticos, fiebre, tos, todo ello puede estar entre los síntomas de la tuberculosis. En los casos más graves se pueden dar expectoraciones de sangre, pérdidas dramáticas de peso o incluso puede llevar a una meningitis, coma y, en último caso, a la muerte.
Todo depende de lo tempranamente que se detecte la enfermedad y de su tratamiento con antibióticos. Un tratamiento definitivamente anticuado, según el doctor Sebastian Dietrich, de la organización “Médicos sin fronteras”: “Los medicamentos que hoy utilizamos para tratar la tuberculosis (y en esto no importa si estamos hablando de Alemania o de países del Tercer Mundo) fueron desarrollados entre 1944 y 1966.
Esto significa que tienen medio siglo de antigüedad, y desde entonces no se ha dado realmente ningún otro medicamento que funcione”.